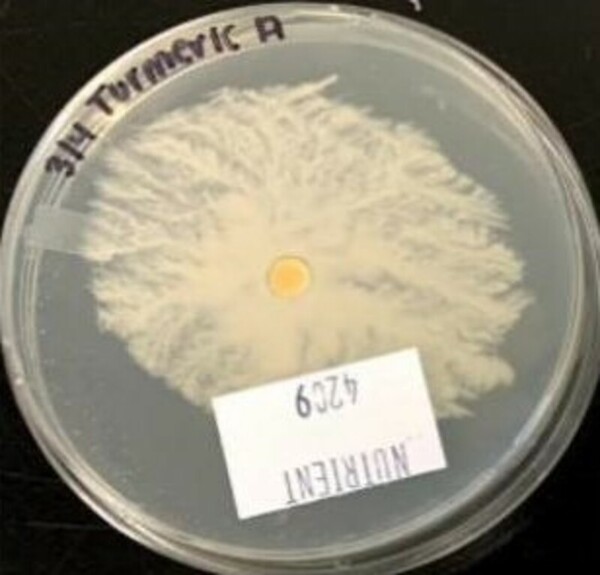
Antibacterial effectiveness of turmeric against gram-positive <i>Staphylococcus epidermidis</i>
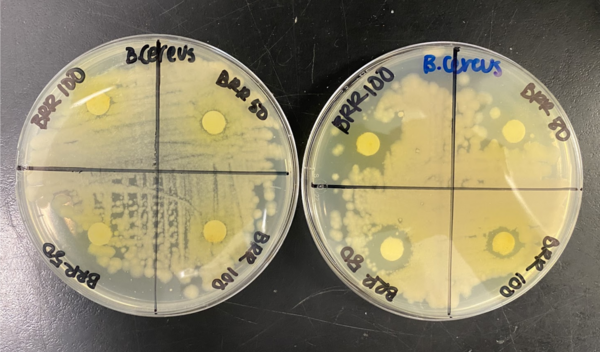
Strain-specific and photochemically-activated antimicrobial activity of berberine and two analogs

Chronic bad breath, or halitosis, is a problem faced by nearly 50% of the general poluation, but existing treatments such as liquid mouthwash or sugar-free gum are imperfect and temporary solutions. In this study, the authors investigate potential alternative treatments using natural ingredients such as Manuka Honey and Licorice root extract. They found that Manuka honey is almost as effective as commercial mouthwashes in reducing the growth of P gingivalis (one of the main bacteria that causes bad breath), while Licorice root extract was largely ineffective. The authors' results suggest that Manuka honey is a promising candidate in the search for new and improved halitosis treatments.
Read More...